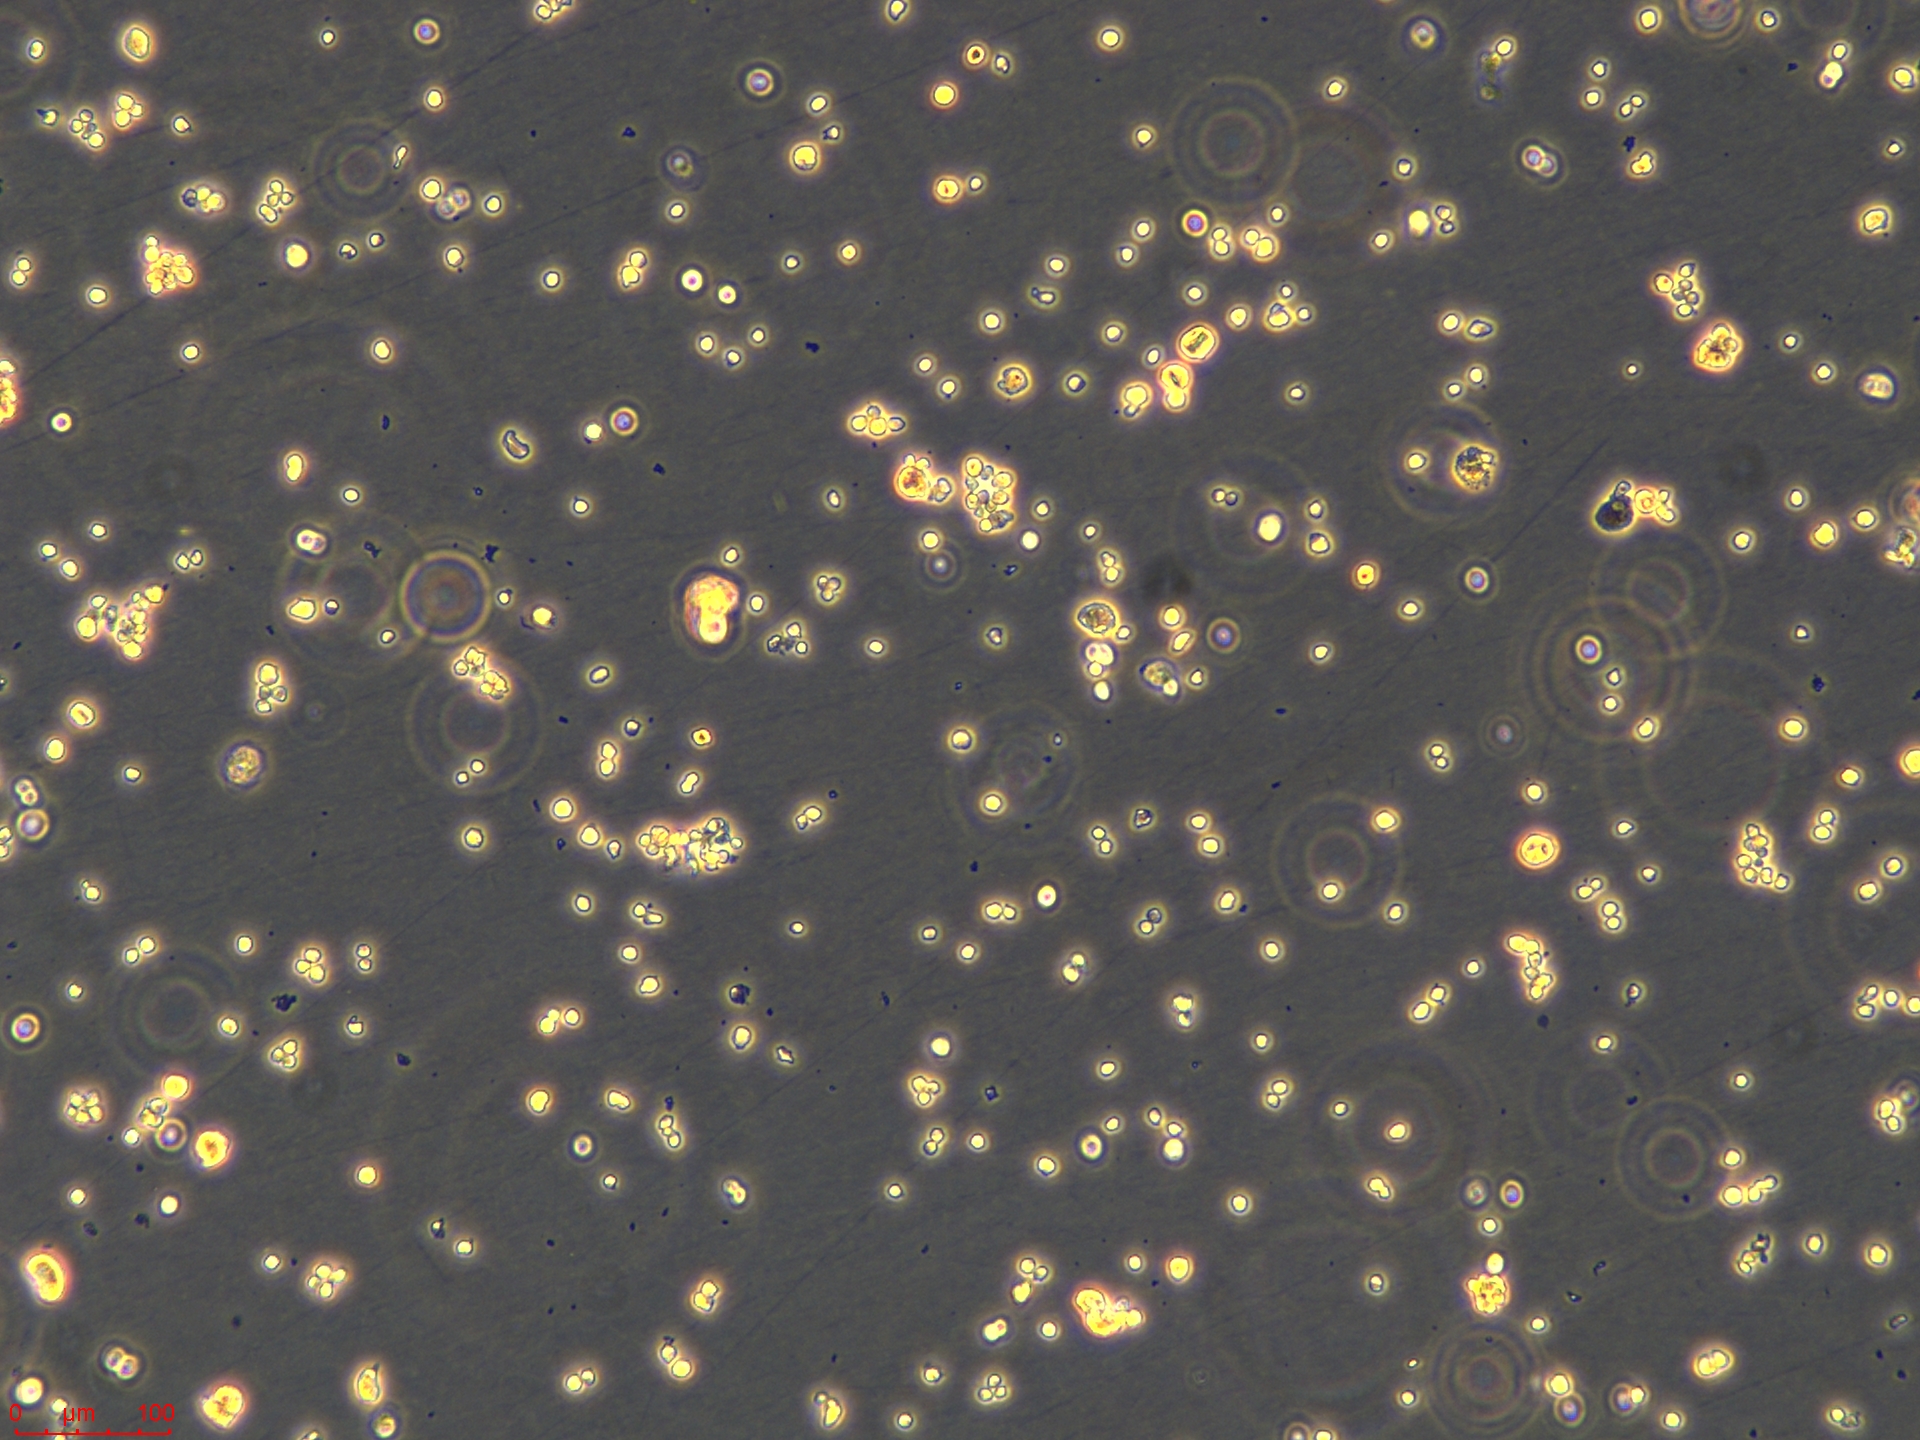
Project_SW1463_ch00.jpg
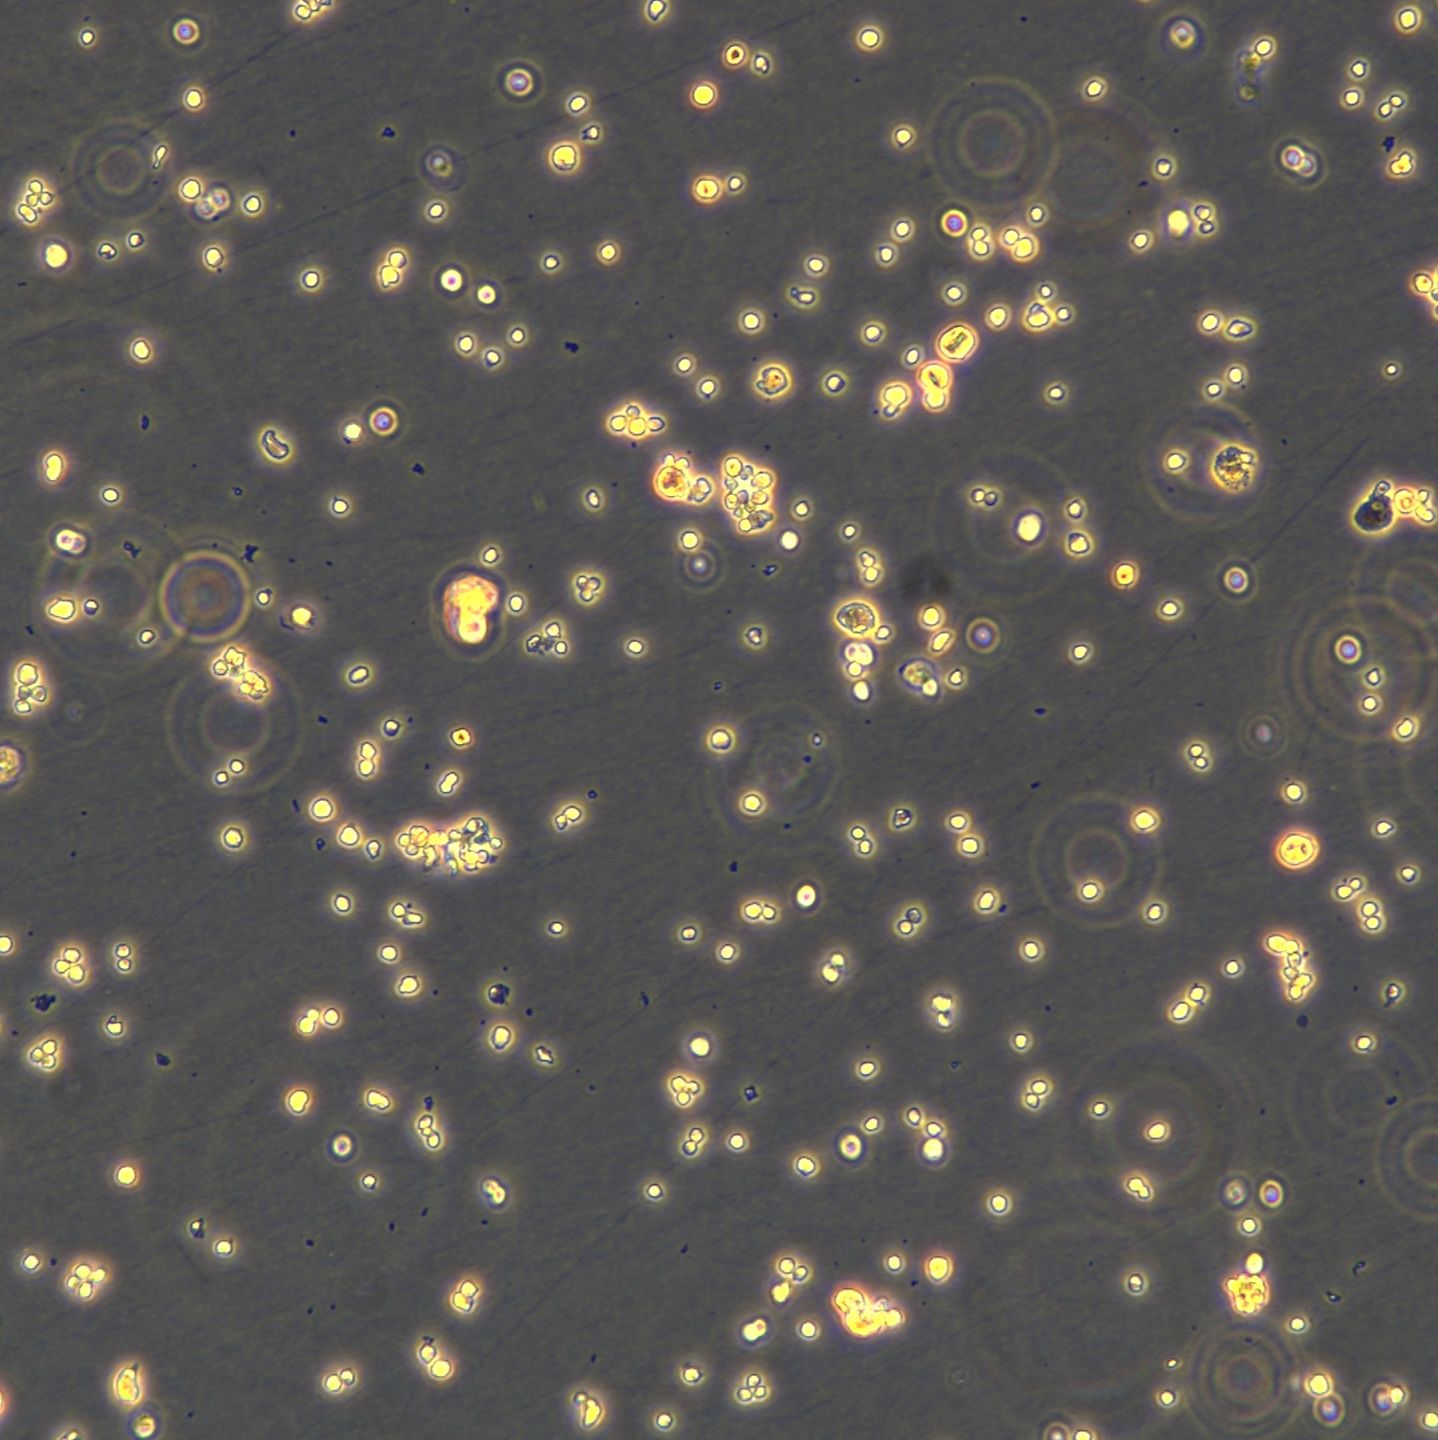
产品封面图

相关产品推荐更多 >
万千商家帮你免费找货
0 人在求购买到急需产品
- 详细信息
- 文献和实验
- 技术资料
- 英文名:
SW1463
- 库存:
100
- 组织来源:
大肠(Large intestine)
- 相关疾病:
直肠腺癌(Rectal adenocarcinoma)
- 物种来源:
人源(Homo sapiens)
- 细胞形态:
上皮细胞(Epithelial)
- 年限:
66岁(66 years)
- 生长状态:
贴壁生长(Adherent)
- 规格:
T25/冻存管
| 货号 | CTCC-001-0232 |
| 种属 | 人源(Homo sapiens) |
| 组织来源 | 大肠(Large intestine) |
| 疾病 | 直肠腺癌(Rectal adenocarcinoma) |
| 年龄 | 66岁(66 years) |
| 培养体系 | 该细胞系培养所用基本培养基为 Dulbecco’s Modified Eagle’s Medium (DMEM), 配置完全培养基时需加入 10%FBS,1% Anti-Anti。 |
| 细胞形态 | 上皮细胞(Epithelial) |
| 生长特性 | 贴壁生长(Adherent) |

风险提示:丁香通仅作为第三方平台,为商家信息发布提供平台空间。用户咨询产品时请注意保护个人信息及财产安全,合理判断,谨慎选购商品,商家和用户对交易行为负责。对于医疗器械类产品,请先查证核实企业经营资质和医疗器械产品注册证情况。
文献和实验细胞治疗是细胞和基因治疗的重要组成部分,它通过使用特定类型的细胞来修复、替换或调节受损的组织和器官。在细胞治疗中,不同类型的细胞因其独特的生物学特性而被广泛应用于多种疾病的治疗。以下是一些常用的细胞类型及其在细胞治疗中的应用。 (1)免疫细胞 免疫细胞是细胞治疗中最重要且研究最多的细胞类型之一,主要包括 T 细胞、自然杀伤细胞(NK 细胞)和树突状细胞(DC 细胞)。 T 细胞:T 细胞是人体免疫系统的核心细胞,具有强大的抗肿瘤能力。CAR-T 细胞疗法是目前最成功的免疫细胞治疗技术
简介 细胞增殖/细胞毒性测定是涉及培养细胞的研究中最常用的测试之一。 其是检查用于治疗的药物浓度的基本初步测试,也是确定各种研究领域(如肿瘤学和细胞死亡)药物疗效和安全性的非常重要的测试。 传统上,WST-8 或 ATP 检测(使用代谢活性作为指标)和 BrdU 或胸腺嘧啶核苷检测(使用 DNA 合成水平作为指标)已用于细胞生长特性的定量评估。 尽管这些检测由于其简易性和吞吐量而对我们有益,但这些检测都是间接评估方法,因此结果可能与实际细胞数无关。 在许多情况下,这些检测是终点评估,有时会
对于贴壁生长的细胞,相对来说比较简单但也很麻烦。以下我主要讨论贴壁生长的细胞。 在讨论之前,大家首先要有一个概念,即洁净区,并不是没有细菌,而是细菌的数量非常少,国家标准100级的洁净标准是浮游菌数不得超过5个每立方米,沉降菌数不得超过1个每培养皿.而国外的标准比我国的还要高一点,要求的数量更少。 所以在我们的洁净操作台里,并不是真正一个细菌都没有的,所以在操作的时候还是要尽量利索迅速地完成操作。尽量减少进入培养体系细菌的数量。 所以处理细菌污染的重要原则就是:无限地稀释细菌的浓度,无限地减少